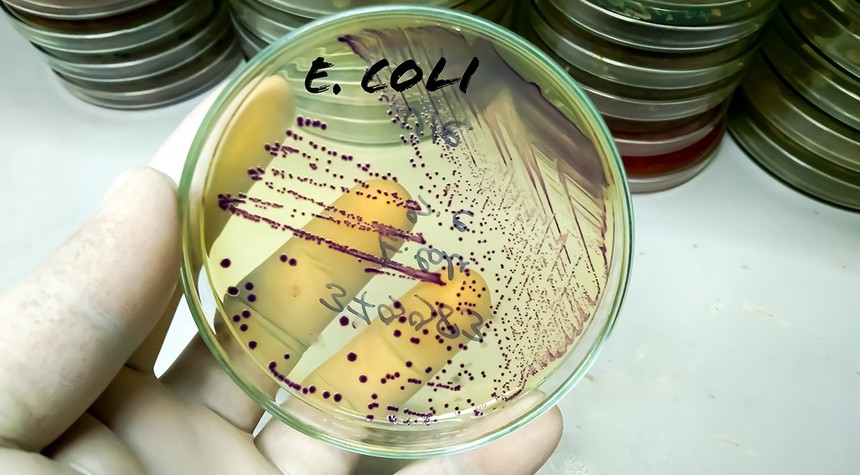
Chinese Researcher Sentenced for Smuggling E. Coli Into United States

A Chinese national working as a postdoctoral researcher at Indiana University has been sentenced to more than four months in federal prison after pleading guilty to smuggling biological materials into the United States.
Youhuang Xiang, 32, admitted to concealing Escherichia coli DNA in a shipment from China that customs documents falsely identified as women’s underwear. The U.S. Attorney’s Office for the Southern District of Indiana announced the conviction this week, marking another case in the ongoing scrutiny of foreign researchers working at American institutions.
The investigation revealed troubling details beyond the smuggling charge itself. Federal authorities discovered that Xiang had been a member of the Chinese Communist Party, an affiliation he deliberately concealed from immigration officials when entering the United States. This deception compounds the severity of his offense and raises questions about the vetting procedures for foreign nationals participating in federally funded research programs.
U.S. Attorney Tom Wheeler emphasized the gravity of such violations, noting that this conduct presents serious threats to both public safety and the nation’s agricultural economy. The concern is well-founded. Biological materials, when improperly handled or introduced outside legitimate scientific channels, can pose significant risks to public health and food security.
The case underscores a broader challenge facing American research institutions. Universities across the nation have welcomed thousands of foreign researchers, many contributing valuable work to scientific advancement. However, this openness has created vulnerabilities that adversarial nations may exploit. The deliberate mislabeling of biological materials and false statements to immigration authorities suggest a calculated effort to circumvent established safety protocols and legal requirements.
Xiang received the suspicious package at his residence in Bloomington, Indiana, in March. Federal investigators became involved after customs officials flagged the shipment’s inconsistencies. The subsequent investigation by the Federal Bureau of Investigation uncovered both the true contents of the package and Xiang’s undisclosed political affiliations.
This conviction arrives amid heightened awareness of foreign influence operations within American academic institutions. Research universities, which often conduct cutting-edge work in sensitive fields including biotechnology, agriculture, and defense-related sciences, have become focal points for counterintelligence concerns.
The four-month prison sentence, while modest, sends a clear message about the consequences of violating import regulations and misrepresenting one’s background to federal authorities. The case also highlights the need for enhanced oversight of international shipments to research facilities and more rigorous verification of foreign researchers’ backgrounds and affiliations.
As American institutions continue to balance the benefits of international scientific collaboration with national security imperatives, cases like Xiang’s serve as reminders that vigilance remains essential. The integrity of federally funded research depends not only on scientific rigor but also on the trustworthiness of those conducting it.
Related: Zuckerberg Devotes Hours Weekly to Training AI Replica of Himself